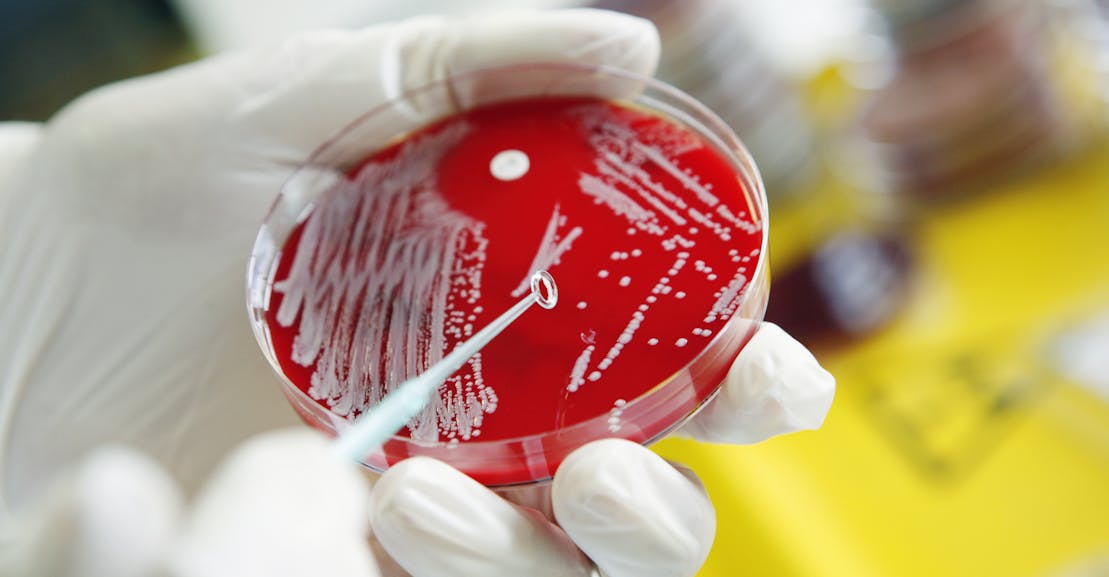
Are Germs the Main Characters in History? Are Germs the Main Characters in History?

Hence then, the article about are germs the main characters in history was published today ( ) and is available on The New Republic ( Middle East ) The editorial team at PressBee has edited and verified it, and it may have been modified, fully republished, or quoted. You can read and follow the updates of this news or article from its original source.
Read More Details
Finally We wish PressBee provided you with enough information of ( Are Germs the Main Characters in History? )
Last updated :
Also on site :
- Aura AI Assistant for Unreal Engine Launches: VR Studio Ships Game in Half the Time with New Agent Capabilities
- Denver Fire Department responds to 3-alarm fire at intersection of Leetsdale Drive and S. Forest Street
- Man accused of placing pipe bombs near GOP and Democratic headquarters in Washington to remain in jail pending trial